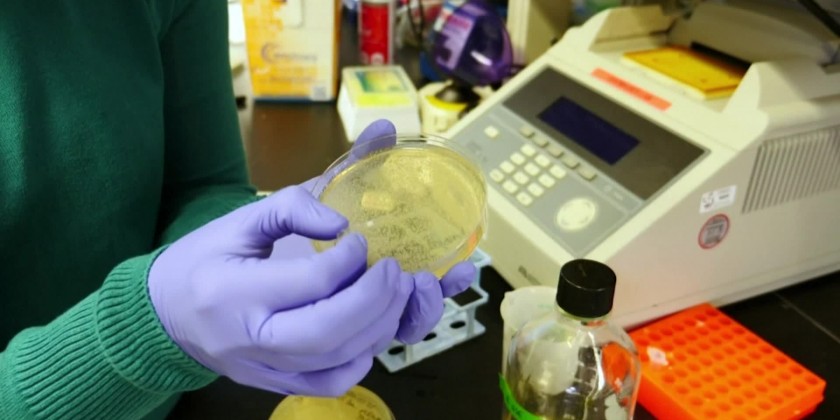

As the death toll from coronavirus mounts, the public health response is ramping up. In Seattle, at the University of Washington's (UW) School of Medicine, researchers at the university's virology division are busy developing a diagnostic test they hope will be able to detect the virus in possible carriers, in the event that virus continues to spread. The test, which scientists are hoping will be ready in a matter of weeks, is based on the latest genomic information about the emerging virus.
As the virus spreads, the White House on Tuesday opted not to suspend flights from China to the United States as a way to deal with the coronavirus outbreak, sources briefed on the matter told Reuters. The coronavirus that originated in the city of Wuhan has killed 132 people in China and spread across the world.
MITV is a broadcast TV brand intended for international and local English speaking consumers, launched on 31st March 2010 based in Yangon.